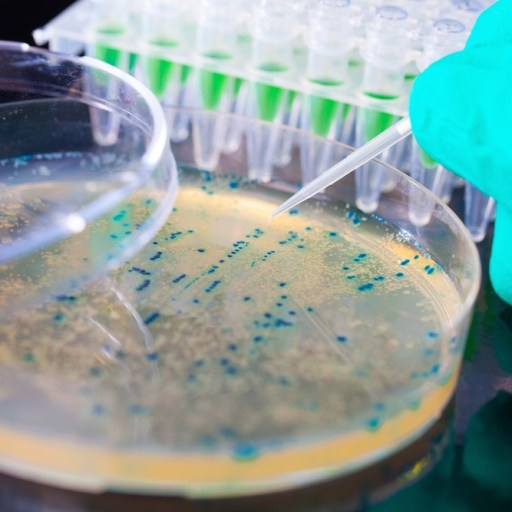

Search
Orion Jones
Managing Editor
Get smarter, faster, for success in the knowledge economy. Like us on https://t.co/6ZFWKpoKLi or visit https://t.co/d7r7dG2XOq
Read Less

According to recent neurological insight, the muse is more apt to reward long periods of sustained concentration than intermittent fits of vision.

Research shows that a good night's sleep—seven hours or more—results in better and more prolonged exercise sessions later that day.

Information technology will change health care in ways similar to how Amazon changed the landscape of the retail industry.

Behavior that would constitute psychosis in adults may be (an unpleasant) part of children's natural emotional development.

Pre-birth nutrition contributes to the "programming" of health, well being, brain development and mental performance and that certain nutrients are important to this process.

The power and agility of our brain was by no means necessary to hunt and kill animals, so why did the thinking organ become such an overachiever?

The public gains made by AI, such as beating chess champions and winning Jeopardy tournaments, have ironically also demonstrated its limits.

Thanks to its high concentration of antioxidants from flavonoids, orange juice has many potential positive effects when it comes to combatting cancer.

Milk does increase weight and length at birth, and there's a possibility that this actually tracks into adult life.

The researchers suggest that the genes may also help establish left-right differences in the brain, which in turn influences handedness.

Being able to prompt this behaviour in the body could one day be used to repair ailing organs including the heart, liver, spinal cord and pancreas.

Having it all is statistically impossible because every single choice you make narrows your choices (the choices you might make in the future), rendering having it all impossible.

The kinds of multitasking abilities required by video games may help stem the tide of cognitive decline which naturally accompanies the aging process.

Making music improves children's ability to relate to each other and to use their intellect in problem-solving situations, according to a new study out of the University of West London.

A 2012 study found that a desire for fame solely for the sake of being famous was the most popular future goal among a group of 10-12 year olds.